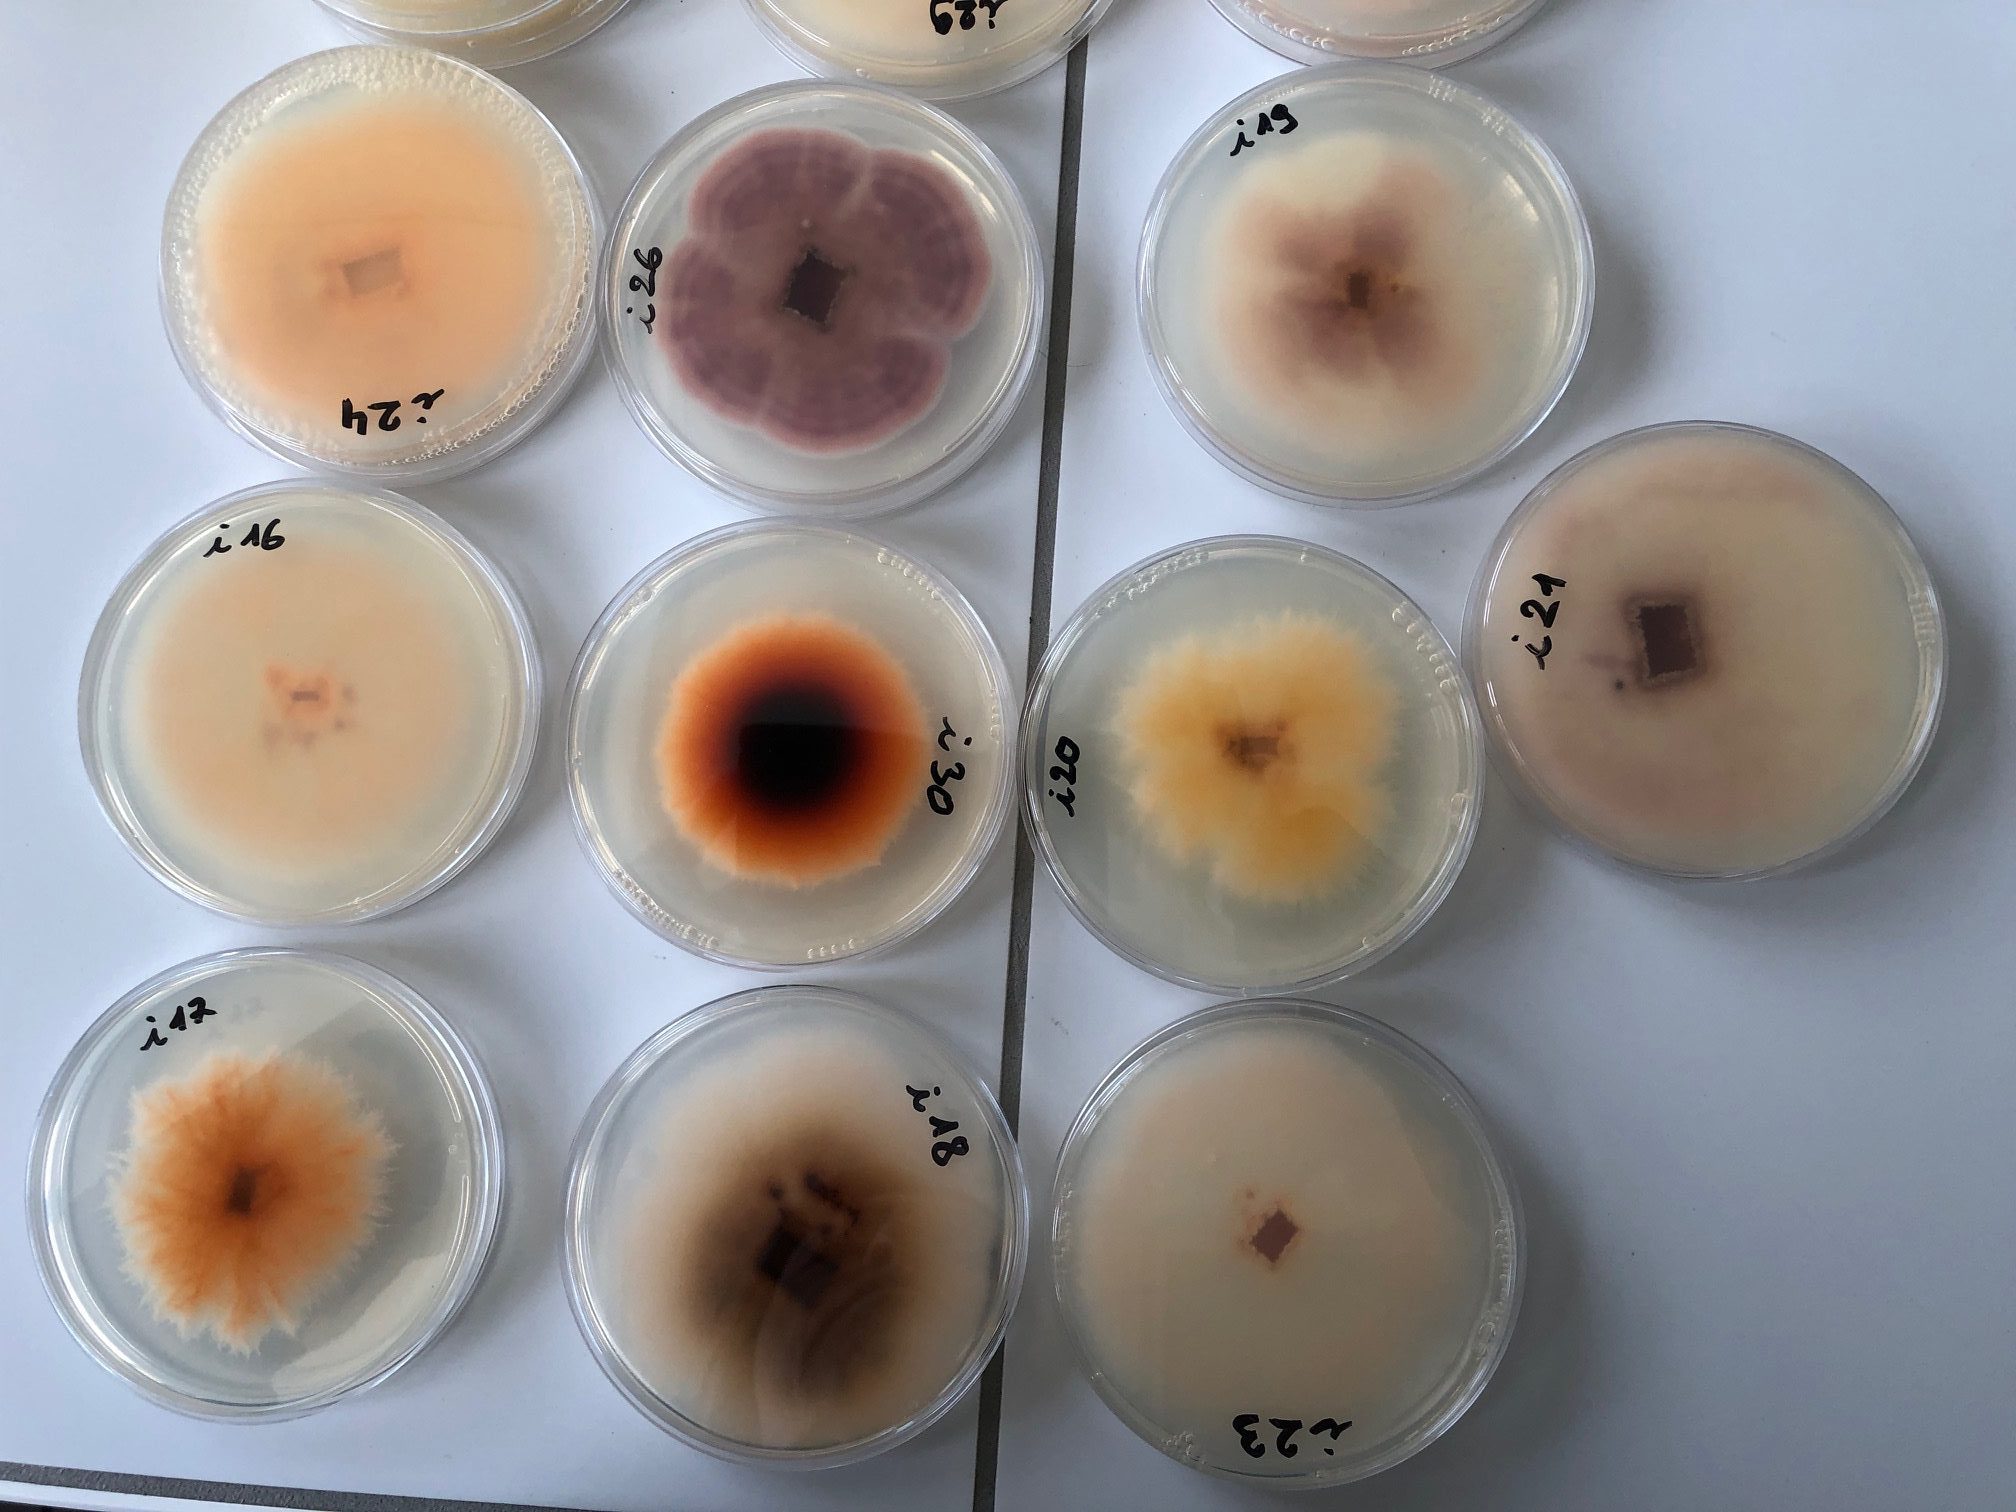
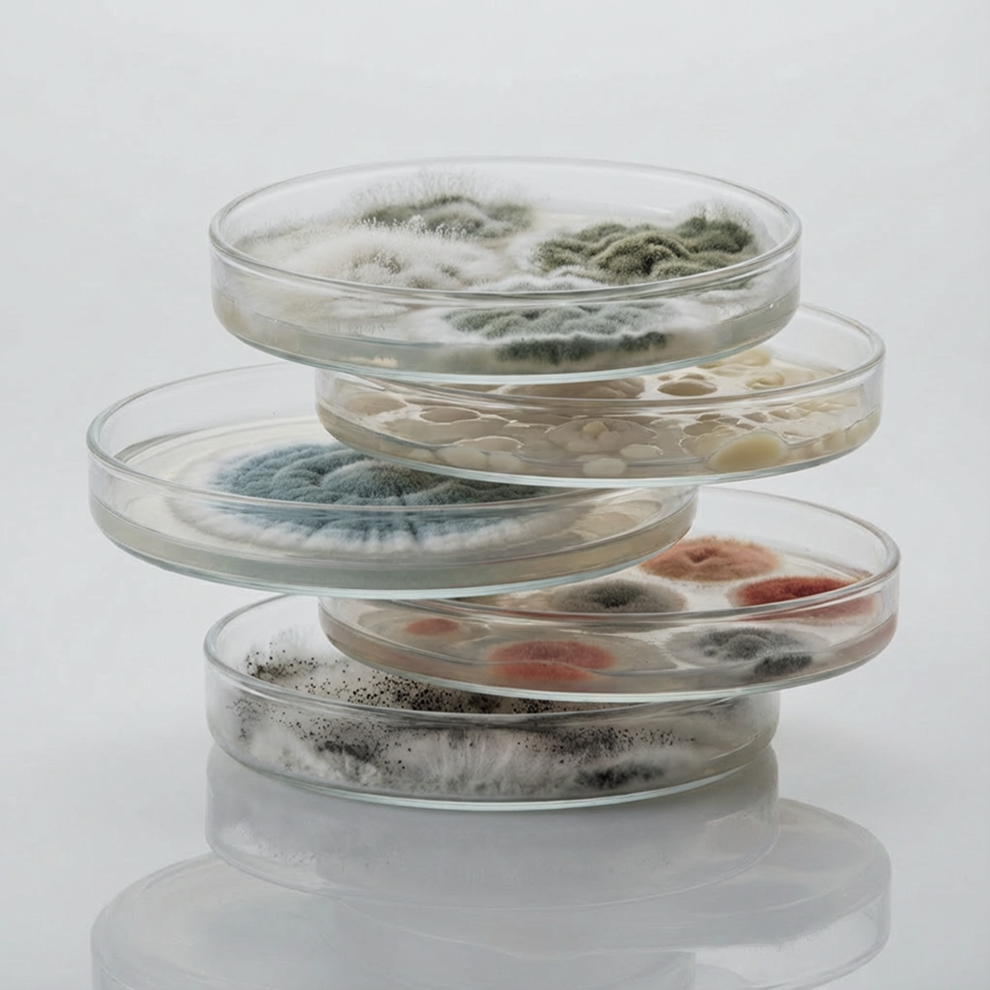

R&D · Microbiologie · Agriculture durable · Procédés FMS
Microbiologie appliquée
au service de
l'agriculture, l'environnement et la nutrition
AGRENE accompagne les entreprises dans le développement de solutions innovantes basées sur les micro-organismes et les substances naturelles : biocontrôle, biostimulants, fermentation et qualité biologique des sols. De la R&D à la mise sur le marché, nous intervenons dans le développement de solutions innovantes en agriculture, environnement et nutrition.